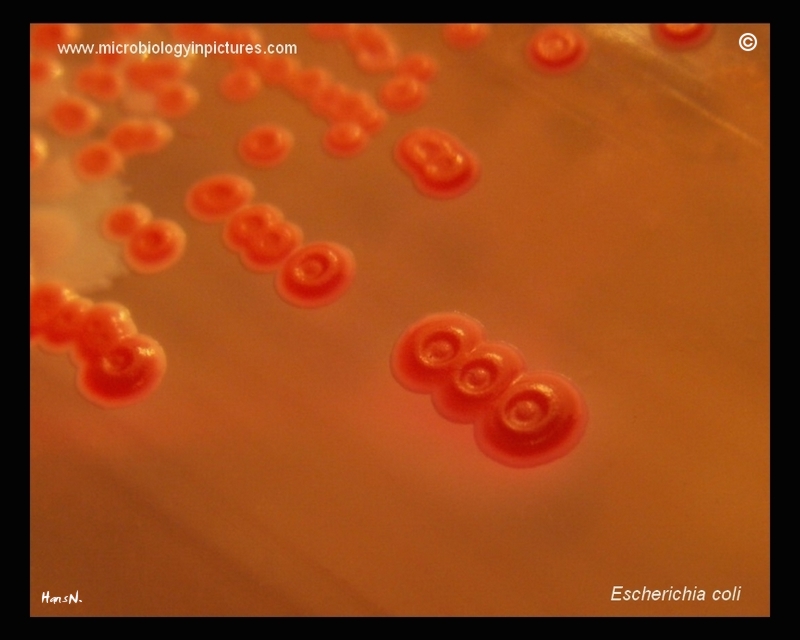

Escherichia coli, lactose-positive, concave colonies on MacConkey agar.
Cultivation 24 hours, 37°C in an aerobic atmosphere.
Escherichia coli, lactose-positive, concave colonies on MacConkey agar.
Cultivation 24 hours, 37°C in an aerobic atmosphere.